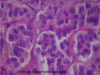

Endo 2 Flashcards
(43 cards)
1
Q

A
Normal Endocrine Pancreas

2
Q

A
DM T1
3
Q

A
DM T2

4
Q

A
DM T2
5
Q

A
DM T2 Complications

6
Q

A
Islet Cell Tumor

7
Q
A
Islet Cell Tumor

8
Q

A
Insulinoma (Islet Cell Tumor)
9
Q

A
Islet Cell Tumors
10
Q

A
Necrolytic Migratory Erythema
11
Q

A
Gastrinoma Triangle
12
Q
A
Normal Parathyroid glands

13
Q

A
Parathyroid hyperplasia

14
Q

A
Parathyroid adenoma
15
Q

A
parathyroid adenoma

16
Q

A
parathyroid adenoma

17
Q

A
parathyroid adenoma

18
Q

A
parathyroid carcinoma

19
Q

A
Normal Adrenal Gland

20
Q

A
Normal Adrenal Gland

21
Q

A
Normal Adrenal Gland

22
Q

A
Normal Adrenal Gland
23
Q

A
Waterhouse-Friderichsen Syndrome

24
Q

A
Waterhouse-Friderichsen Syndrome

25

Waterhouse-Friderichsen Syndrome
26

Adrenal Tuberculosis

27

Adrenal Tuberculosis

28

Adrenal Tuberculosis
29

Adrenal Cortical Adenoma

30

Adrenal Cortical Adenoma

31

Adrenal Cortical Adenoma

32

Adrenal Cortical Adenoma
33

Adrenal Cortical Carcinoma

34

Adrenal Cortical Carcinoma

35

Adrenal Cortical Carcinoma

36

Adrenal Cortical Carcinoma

37

Pheochromocytoma

38

Pheochromocytoma

39

Pheochromocytoma

40

Neuroblastoma

41

Neuroblastoma
42

Neuroblastoma

43

MEN 2B



